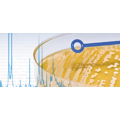

Samostatně dodávaná knihovna Fungi Library.
Kompletní software pro IVD rychlou a automatizovanou identifikaci mikroorganizmů.

Samostatně dodávaná knihovna Mycobacterium Library.

Samostatně dodávaná knihovna pro vysoce patogenní mikroorganismy skupiny Biosafety Level 3.